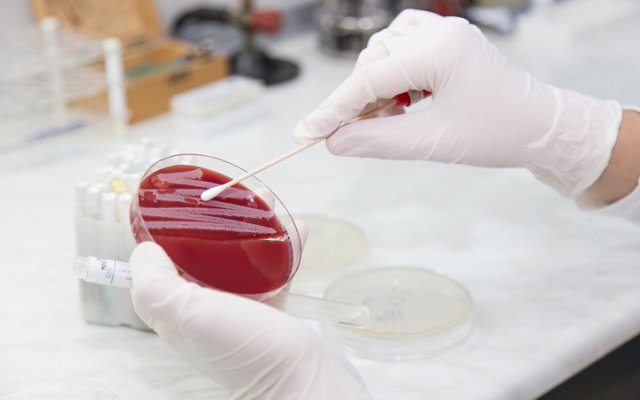
Recce Pharmaceuticals locks-in US patent for synthetic antibiotic to target growing superbug problem

Recce Pharmaceuticals (ASX: RCE) has locked-in a US patent for its broad-spectrum synthetic antibiotics, paving the way for the company to shoulder into the US$42.33 billion global antibiotic market.
The new class of synthetic antibiotics were developed to address the mounting existence of antibiotic-resistant superbugs.
Following from the company’s first ever wholly-owned US patent, the US Patents and Trademarks Office has now granted Recce 23 claims for its patent US 10,226,482 B2 Copolymer and Method for Treatment of Bacterial Infection.
The patent includes the company’s lead candidate RECCE®327, which was created to tread blood infections and sepsis caused by E. coli and S. aureus bacteria – including superbug forms.
Positive results have been achieved using the candidate during pre-clinical testing in laboratories and animal models.
Recce has established a manufacturing facility in Australia and is looking at teaming up with clinical research partners in the US.
The company has developed a process to manufacture RECCE®327 ahead of human clinical trials.
Superbug problem
Sepsis, septicaemia or blood poisoning is believed to affect 30 million people world-wide every year, with the health complication proving fatal for around one-third of sufferers.
The disease kills more people than breast and prostate cancer, and HIV/AIDs, combined.
According to Recce executive director James Graham, the company’s RECCE® tackles superbugs by adhering to the bacteria’s outer membrane. It causes the cell to separate and the bacteria inside to burst.
Whereas with traditional antibiotics, if the bacteria mutates as it does with superbugs, natural antibiotics no longer work.
Directors back Recce
Earlier this month, Mr Graham threw his personal support behind the company and scooped up 650,000 fully paid ordinary shares at $0.1546 each.
Mr Graham paid $100,460 for the stake, which adds to his existing 3.65 million-worth of indirectly and directly held ordinary shares.
The share buy-up follows his unsecured short-term loan of $100,000 that was provided to Recce in January.
Meanwhile, during December 2018, Recce founder and chairman Dr Graham Melrose offered his support to the company via a $200,000 unsecured loan.
By mid-afternoon trade, shares in Recce had reached $0.17 – up more than 13%.